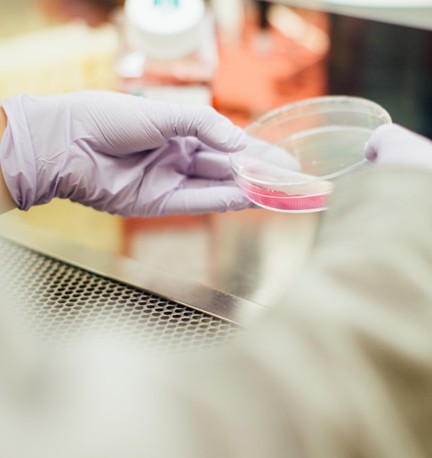

In enzyme-linked immunosorbent assays (ELISAs) that rely on polyclonal antibodies, non-specific binding remains a major obstacle, often causing elevated background noise, decreased assay sensitivity, and less reliable data. Effectively minimizing these unwanted interactions is crucial for obtaining accurate and reproducible results.
By implementing proven techniques - from choosing the right blocking reagent to fine-tuning washing steps and optimizing antibody concentrations - you can significantly improve your assay’s performance. This article will walk you through essential strategies to reduce non-specific binding in polyclonal antibody-based ELISAs, ensuring cleaner results whether you’re working with research peptides or other complex samples.
An effective blocking step is essential for reducing non-specific binding in polyclonal antibody-based ELISA tests, as it helps prevent detection antibodies from adhering to the uncoated surfaces of the assay plate. Choosing the right blocking reagent can significantly improve assay sensitivity and reduce background signal.
Non-protein blockers, such as synthetic formulations like Synblock, are particularly useful when cross-reactivity with traditional protein blockers becomes an issue - especially in assays involving sensitive detection systems or diverse sample types. Among protein-based options, casein often outperforms bovine serum albumin (BSA) in minimizing background, with some studies reporting up to an 86% reduction in non-specific signal when using casein over BSA.
However, if BSA is preferred due to cost or availability, it’s important to select a highly purified, IgG- and protease-free grade to prevent the introduction of unwanted antibody targets or enzymatic degradation.
Each blocker should be evaluated in the context of your specific assay, particularly when working with sensitive targets like research peptides, to ensure optimal performance and reproducibility.
Thorough washing is a critical step in minimizing non-specific binding in polyclonal antibody-based ELISA tests, as it removes loosely or weakly bound proteins that can contribute to background noise and reduce assay specificity.
To effectively disrupt non-specific hydrophobic or ionic interactions, it is recommended to use a washing buffer such as phosphate-buffered saline with Tween-20 (PBST), typically at a concentration of 0.05–0.1%. The inclusion of a mild detergent like Tween-20 helps break surface interactions that are not epitope-specific, allowing for cleaner results.
A minimum of five wash cycles should be performed, using generous volumes of buffer - generally around 300–400 μL per well - to ensure that all residual unbound or weakly adhered molecules are removed. While manual washing techniques can be effective when performed with precision, automated plate washers are strongly preferred for ensuring consistency and repeatability across wells and experiments.
This consistency is especially important when working with complex samples or highly sensitive detection systems, where even minor variations in wash technique can impact reproducibility and assay outcomes.
Finding the friendliest pairing of antibodies and concentrations is key:

Adjusting buffer composition and assay conditions is a crucial strategy for minimizing non-specific binding in ELISA assays that use polyclonal antibodies. The chemical environment created by your buffers can significantly impact antibody-antigen interactions - both specific and non-specific. One effective approach is to increase the ionic strength of the buffer, typically by adding sodium chloride (NaCl).
This addition helps disrupt weak, non-specific ionic interactions between charged molecules without interfering with the strong, high-affinity binding between the target antigen and the detection antibody. Furthermore, incorporating carrier proteins such as bovine serum albumin (BSA) or casein into the antibody diluent can effectively block reactive "sticky" surfaces and reduce unwanted interactions by occupying potential non-target binding sites. These carrier proteins act as decoys, saturating surfaces and minimizing opportunities for antibodies to adhere non-specifically.
In both the blocking and wash steps, the addition of non-ionic detergents like Tween-20 at low concentrations (typically 0.05–0.1%) is highly recommended. Tween-20 reduces hydrophobic interactions by disrupting lipid-like or surface-binding tendencies of proteins, making it particularly effective at lowering background noise and improving the signal-to-noise ratio of your assay. By carefully optimizing buffer composition, researchers can improve assay precision, increase reproducibility, and enhance the overall sensitivity of ELISA tests.
Not all ELISA plates behave the same:
When standard options fall short:
Effective assays rely on SMART experimental design:
Polyclonal antibodies and reagents can vary between batches:
Use the systematic approach outlined in Biocompare and Thermo Fisher resources:
For persistent background issues:
Non‑specific binding in ELISA assays can lead to false positives, poor reproducibility, and wasted resources. For polyclonal antibody–based systems, which are prone to broader binding patterns, mastering these techniques is essential to producing reliable data. When meticulously optimized:
Minimizing non-specific binding in polyclonal antibody-based ELISAs hinges on mastering three essential pillars. First, optimized blocking - whether using carefully selected proteins like casein or synthetic blockers - forms a critical barrier that prevents antibodies from adhering to non-target surfaces. Second, stringent washing protocols that incorporate detergent-rich buffers help remove weakly bound proteins, further reducing background noise. Third, meticulous validation of all reagents, plate materials, and assay conditions ensures consistency and reliability throughout the testing process.
By implementing these strategies together, what might otherwise be a noisy and unreliable assay transforms into a powerful, data-driven tool perfectly suited for applications such as diagnostics, vaccine validation, biomarker discovery, and beyond.